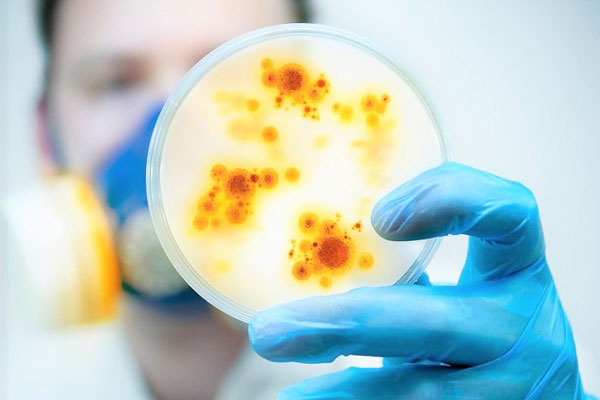
pic_1

Архив
07.04.2022
В РЯЗГМУ ОБСУДЯТ ВЕДЕНИЕ ПАЦИЕНТОВ С ИНФЕКЦИОННЫМИ ЗАБОЛЕВАНИЯМИ
Рязанский государственный медицинский университет имени академика И.П. Павлова приглашает принять участие в работе Всероссийской конференции с международным участием «Инфекционные заболевания взрослых и детей в условиях пандемии COVID-19». Мероприятие состоится 13 и 14 апреля 2022 года.
Ведущие эксперты обсудят герпесвирусные инфекции в период пандемии, тактику амбулаторного и стационарного ведения пациентов COVID-19, междисциплинарные аспекты ведения пациентов, лонг-ковид синдром и многие другие актуальные вопросы инфекционных болезней.
Открытие конференции пройдет в 10.00 в зале ученого совета в медико-профилактическом корпусе по адресу: г. Рязань, ул. Высоковольтная, 7, корпус 1.